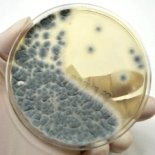

Find a Mold Specialist Now
Click or Call, Toll-Free 24/7
Some people with a do-it-yourself mindset prefer to buy black mold test kits to see if there is mold present in their home. If you decide to get a black mold testing kit, keep in mind that it can show some indication of mold spores that are present, but it is best to work with a professional mold specialist that can determine how severe the problem is.
Black mold can grow in many places. The perfect environment for mold growth is an area that is damp or wet for an extended period of time. When black mold begins to grow in these areas, it is difficult to eradicate because the mold spores are microscopic and they can travel to other areas of the building.
Even though the mold spores can't immediately be identified with the naked eye, the danger should not be overlooked. When mold spores are present, they can negatively affect many areas of health including respiratory, digestive, and even fertility health. Symptoms start out mild, and most people don't realize that they are suffering symptoms of mold exposure. Over time the symptoms will become worse, and severe cases of mold exposure can even result in death.
In order to avoid these serious health conditions, it is important to hire a professional or learn how to use black mold test kits in order to identify whether or not there is mold present in the building.
The first type of test kit tests for mold on surfaces. Read the instructions thoroughly to be sure that you complete the test correctly. Most of the kits will require you to swab the affected area with a Q-tip, and then rub the Q-tip in a dish that contains a substance that helps the mold grow. If the testing dish begins to grow mold, then you will know that mold is present on the surface that was swabbed.
The second type of black mold test kits that are available focus on testing the air for mold spores that may be present. Like the first type of test kit, these kits use a dish with a mold growth substance to see if mold colonies grow. Instead of using a Q-tip, though, the dish is allowed to sit open in the room for about an hour. Once the hour is complete, a lid is placed on the dish and it should be checked in a few days to see if mold has grown.
The drawback to both of these types of tests is the fact that they cannot identify the type of mold that is present. Additional testing is needed to determine the exact type of mold that you are dealing with. They also will not tell you how severe the problem is.
The home testing kits can be a good start to determine if mold is present, but the best approach is to work with a professional mold tester who can identify the extent of the problem. These professionals are trained to know where mold typically grows, and they can advise you on the proper cleanup process to get rid of the mold completely.
Don't be fooled into thinking that the mold cleanup process is as simple as wiping down the area with a rag and household cleaner, because standard cleaning techniques will not kill all the mold spores. Professional equipment needs to be used in order to prevent cross contamination, and also help you to avoid future mold problems.
To find professionals that can test for mold in your area, click here.
Return From Black Mold Test Kits To Our Main Black Mold Test Page
Black Mold Health Symptoms Home Page